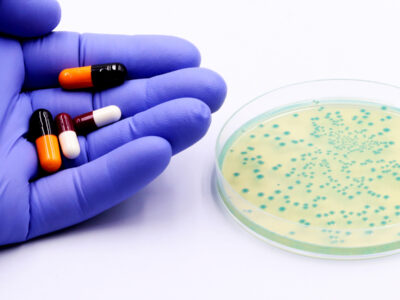

Unsere Artikel aus den Newslettern
-
 Sehkraft in GefahrZu den häufigsten Augenerkrankungen in der Schweiz gehören der graue und der grüne Star. Lesen Sie, wie die Krankheiten entstehen, was sie voneinander unterscheidet, und…
Sehkraft in GefahrZu den häufigsten Augenerkrankungen in der Schweiz gehören der graue und der grüne Star. Lesen Sie, wie die Krankheiten entstehen, was sie voneinander unterscheidet, und… -
 Epi-Food – Nahrung für die GeneEpi-Food ist angesagt: Das Ernährungskonzept der Epigenetik zielt darauf ab, Gene durch eine gesunde Ernährung und Lebensweise positiv zu beeinflussen. Was bedeutet das konkret und…
Epi-Food – Nahrung für die GeneEpi-Food ist angesagt: Das Ernährungskonzept der Epigenetik zielt darauf ab, Gene durch eine gesunde Ernährung und Lebensweise positiv zu beeinflussen. Was bedeutet das konkret und… -
 Ein Wandel in der GesundheitsversorgungIm Schweizer Gesundheitssystem spielen Apotheken eine immer zentralere Rolle. Neben der Ausgabe rezeptfreier Medikamente oder Nahrungsergänzungsmittel und der Beratung der Kundschaft erweitern sie ihr Leistungsspektrum zunehmend. Welche Dienstleistungen bieten Apotheken konkret…
Ein Wandel in der GesundheitsversorgungIm Schweizer Gesundheitssystem spielen Apotheken eine immer zentralere Rolle. Neben der Ausgabe rezeptfreier Medikamente oder Nahrungsergänzungsmittel und der Beratung der Kundschaft erweitern sie ihr Leistungsspektrum zunehmend. Welche Dienstleistungen bieten Apotheken konkret… -
 Geschenke mit KlasseVerschenken Sie Gesundheit, Schönheit und Wohlbefinden! Mit Geschenken aus der Apotheke können Sie Persönliches mit Praktischem und Sinnvollem verbinden und Familie und Freunden eine…
Geschenke mit KlasseVerschenken Sie Gesundheit, Schönheit und Wohlbefinden! Mit Geschenken aus der Apotheke können Sie Persönliches mit Praktischem und Sinnvollem verbinden und Familie und Freunden eine… -
Wenn Bakterien resistent werdenAntibiotika sind Substanzen, die häufig zur Vorbeugung und Behandlung von Infektionen eingesetzt werden. Durch massenhaften und unsachgemässen Einsatz werden heute aber immer mehr Bakterien unempfindlich gegenüber…
Wenn Bakterien resistent werdenAntibiotika sind Substanzen, die häufig zur Vorbeugung und Behandlung von Infektionen eingesetzt werden. Durch massenhaften und unsachgemässen Einsatz werden heute aber immer mehr Bakterien unempfindlich gegenüber… -
 Fit und fokussiert ins neue SchuljahrDer Schulbeginn bringt viel Neues mit sich: Lernstoff, Prüfungen und Herausforderungen. Doch mit der richtigen Vorbereitung und ein paar Tipps aus der Apotheke lassen sich…
Fit und fokussiert ins neue SchuljahrDer Schulbeginn bringt viel Neues mit sich: Lernstoff, Prüfungen und Herausforderungen. Doch mit der richtigen Vorbereitung und ein paar Tipps aus der Apotheke lassen sich… -
 Prävention in der ApothekeFür eine Schürfwunde, eine laufende Nase, ein schmerzendes Knie oder den Medikamentenbezug auf Rezept ist Ihre Apotheke die erste Anlaufstelle. Sie ist aber nicht nur…
Prävention in der ApothekeFür eine Schürfwunde, eine laufende Nase, ein schmerzendes Knie oder den Medikamentenbezug auf Rezept ist Ihre Apotheke die erste Anlaufstelle. Sie ist aber nicht nur… -
 Künstliche Intelligenz in der ApothekeDie Lancierung von ChatGPT war im Jahr 2023 in aller Munde. Zahlreiche Branchen mussten sich an die neue Situation anpassen. Wie steht es mit dem…
Künstliche Intelligenz in der ApothekeDie Lancierung von ChatGPT war im Jahr 2023 in aller Munde. Zahlreiche Branchen mussten sich an die neue Situation anpassen. Wie steht es mit dem… -
 Ein Wandel in der GesundheitsversorgungIm Schweizer Gesundheitssystem spielen Apotheken eine immer zentralere Rolle. Neben der Ausgabe rezeptfreier Medikamente oder Nahrungsergänzungsmittel und der Beratung der Kundschaft erweitern sie ihr Leistungsspektrum…
Ein Wandel in der GesundheitsversorgungIm Schweizer Gesundheitssystem spielen Apotheken eine immer zentralere Rolle. Neben der Ausgabe rezeptfreier Medikamente oder Nahrungsergänzungsmittel und der Beratung der Kundschaft erweitern sie ihr Leistungsspektrum… -
 Heuschnupfen – welche Mittel gibt es in der Apotheke?Gehören Sie auch zu den Menschen, die den Frühling fürchten, weil die Pollen Sie ausbremsen? Frühlingsallergien, die für gewöhnlich als Heuschnupfen bezeichnet werden, sind häufig.
Heuschnupfen – welche Mittel gibt es in der Apotheke?Gehören Sie auch zu den Menschen, die den Frühling fürchten, weil die Pollen Sie ausbremsen? Frühlingsallergien, die für gewöhnlich als Heuschnupfen bezeichnet werden, sind häufig. -
 Medikamente im AlterFür ältere Menschen ist die Beratung durch Apothekerinnen und Apotheker besonders wichtig. Sie helfen mit Fachwissen, nützlichen Tipps und praktischer Unterstützung bei der Therapie. …
Medikamente im AlterFür ältere Menschen ist die Beratung durch Apothekerinnen und Apotheker besonders wichtig. Sie helfen mit Fachwissen, nützlichen Tipps und praktischer Unterstützung bei der Therapie. … -
 Gerüstet für kleinere NotfälleOb unterwegs im Wald, beim Wandern in den Bergen oder im ganz normalen Familien- und Arbeitsalltag: Was alles können Sie einfach und platzsparend für…
Gerüstet für kleinere NotfälleOb unterwegs im Wald, beim Wandern in den Bergen oder im ganz normalen Familien- und Arbeitsalltag: Was alles können Sie einfach und platzsparend für… -
 Wertvolle Unterstützung aus der ApothekeNach einem Spitalaufenthalt oder bei verminderter Mobilität aufgrund des Alters können verschiedene Hilfsmittel die Selbständigkeit im Alltag erhöhen. Apothekerinnen und Apotheker spielen dabei eine zentrale…
Wertvolle Unterstützung aus der ApothekeNach einem Spitalaufenthalt oder bei verminderter Mobilität aufgrund des Alters können verschiedene Hilfsmittel die Selbständigkeit im Alltag erhöhen. Apothekerinnen und Apotheker spielen dabei eine zentrale… -
 «Zu verbrauchen bis» – was uns Haltbarkeitsangaben bei Medikamenten sagenMedikamente sind in der Schweiz zwingend mit einem Verfallsdatum zu versehen. Der Gebrauch von abgelaufenen Arzneimitteln ist heikel. Medikamente haben typischerweise…
«Zu verbrauchen bis» – was uns Haltbarkeitsangaben bei Medikamenten sagenMedikamente sind in der Schweiz zwingend mit einem Verfallsdatum zu versehen. Der Gebrauch von abgelaufenen Arzneimitteln ist heikel. Medikamente haben typischerweise… -
 Abnehmen – die Apotheke hilftWohl jeder wollte schon mal abnehmen. Doch kaum sind ein paar Kilo weg, hat man sie wieder auf den Hüften. Dranbleiben! Mit Beharrlichkeit und…
Abnehmen – die Apotheke hilftWohl jeder wollte schon mal abnehmen. Doch kaum sind ein paar Kilo weg, hat man sie wieder auf den Hüften. Dranbleiben! Mit Beharrlichkeit und… -
 Alkoholhaltige Medikamente und ihre RisikenAlkohol ist in der Rezeptur bestimmter Medikamente manchmal erforderlich, meist zur Gewährleistung der Haltbarkeit. Auch wenn er nur in kleinsten Mengen vorhanden ist, bei einigen…
Alkoholhaltige Medikamente und ihre RisikenAlkohol ist in der Rezeptur bestimmter Medikamente manchmal erforderlich, meist zur Gewährleistung der Haltbarkeit. Auch wenn er nur in kleinsten Mengen vorhanden ist, bei einigen… -
 Schweigepflicht gilt auch für die ApothekerApothekerinnen und Apotheker unterstehen, genauso wie Ärzte, Ärztinnen und andere Medizinalpersonen, der beruflichen Schweigepflicht. Was ihnen Kunden anvertrauen, bleibt vertraulich. Wenn Kundinnen und Kunden in…
Schweigepflicht gilt auch für die ApothekerApothekerinnen und Apotheker unterstehen, genauso wie Ärzte, Ärztinnen und andere Medizinalpersonen, der beruflichen Schweigepflicht. Was ihnen Kunden anvertrauen, bleibt vertraulich. Wenn Kundinnen und Kunden in… -
 Geschenk-Shopping in der ApothekeBald ist sie da, die Weihnachtszeit. Es ist der beste Zeitpunkt, danke zu sagen und die Liebsten zu beschenken. Die Apotheken bieten so Einiges an,…
Geschenk-Shopping in der ApothekeBald ist sie da, die Weihnachtszeit. Es ist der beste Zeitpunkt, danke zu sagen und die Liebsten zu beschenken. Die Apotheken bieten so Einiges an,… -
 Medikamentenvergiftungen – diese Gefahr bestehtDer unscheinbare, weisse Notfallschrank mit einem kleinen roten Kreuz drauf: Eine Hausapotheke, die heute fast jede und jeder hat. Sie beinhaltet eine Sammlung an Medikamenten,…
Medikamentenvergiftungen – diese Gefahr bestehtDer unscheinbare, weisse Notfallschrank mit einem kleinen roten Kreuz drauf: Eine Hausapotheke, die heute fast jede und jeder hat. Sie beinhaltet eine Sammlung an Medikamenten,… -
 Zusammenarbeit als ErfolgsfaktorWenn Apotheker und Ärzte zusammenarbeiten, ist dies für den Patienten auf den ersten Blick oft nicht sichtbar. Ohne Frage profitiert er aber davon, gerade bei…
Zusammenarbeit als ErfolgsfaktorWenn Apotheker und Ärzte zusammenarbeiten, ist dies für den Patienten auf den ersten Blick oft nicht sichtbar. Ohne Frage profitiert er aber davon, gerade bei…

